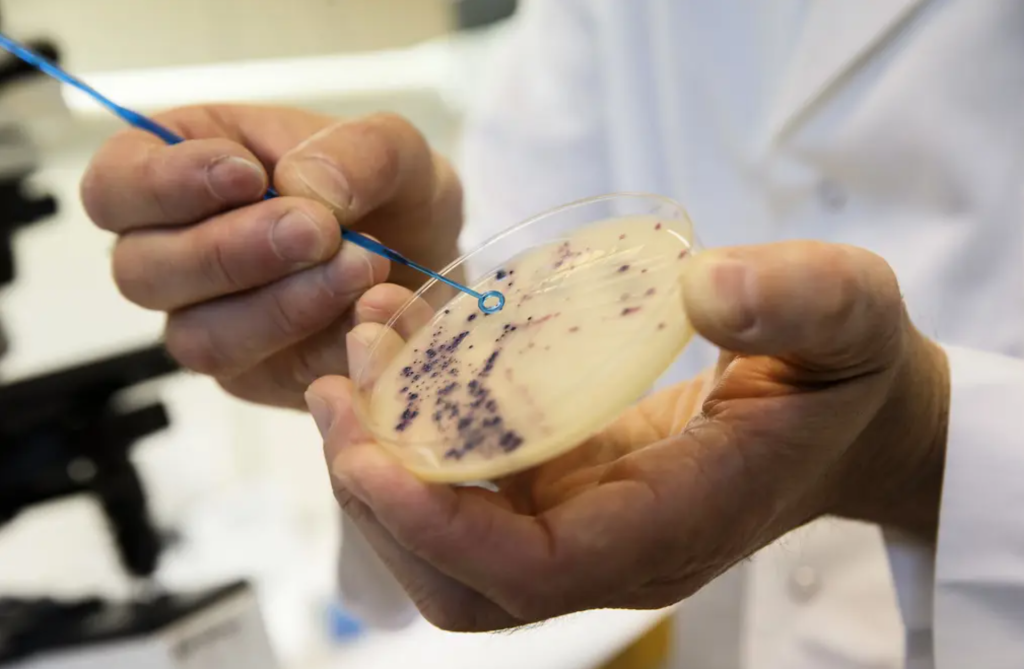

Antibiotikaresistens är ett av de största globala hoten mot folkhälsan. En ny rapport från Läkemedelsverket visar att miljön kan spela en betydligt större roll i spridningen av antibiotikaresistens än man tidigare trott.


Ekberg
Antibiotikaresistens pekas redan i dag ut som ett av de största hoten mot global folkhälsa. Men fokus har länge legat på överanvändning av antibiotika inom vård och djurhållning. Nu lyfts en tredje viktig faktor fram – miljön.
Flera källor sprider resistens
Enligt rapporten från Läkemedelsverket sprids både antibiotikarester och resistenta bakterier via flera olika vägar – från människor, djur, livsmedelsproduktion och läkemedelsindustri. När dessa ämnen når naturen kan de bidra till att nya resistenta bakterier utvecklas och sprids vidare.
Det handlar till exempel om utsläpp i vatten från fabriker eller avloppssystem, där bakterier kan mötas och utbyta resistensgener.
Över en miljon dödsfall varje år
Konsekvenserna är allvarliga. Antibiotikaresistens orsakar redan över en miljon dödsfall globalt varje år och riskerar att försvåra behandlingar av allt från lunginflammation till cancerbehandlingar.
Om utvecklingen fortsätter kan vanliga infektioner bli livshotande igen – något som särskilt drabbar äldre och personer med nedsatt immunförsvar.
Sverige i bättre läge – men beroende av andra
Sverige har relativt låg antibiotikaanvändning och väl fungerande vatten- och avloppssystem, vilket minskar risken för spridning via miljön här hemma.
Samtidigt finns ett globalt beroende – nästan all antibiotika som används i Sverige tillverkas utomlands. Det innebär att utsläpp i andra länder kan påverka även oss.
“Sverige har ett moraliskt ansvar att bidra till minskade utsläpp från antibiotikaproduktion i andra länder, eftersom nästan all antibiotika som används i Sverige importeras och när resistens väl uppkommer begränsas inte spridningen av landsgränser”, skriver Läkemedelsverkt.
Kräver ny strategi
Rapporten pekar på flera möjliga åtgärder, som bättre kontroll av utsläpp från industri och sjukhus samt ökad övervakning via avloppsvatten.
Det finns fortfarande stora kunskapsluckor, till exempel kring hur olika källor faktiskt påverkar människors exponering och vilka åtgärder som är mest effektiva.
Slutsatsen är att kampen mot antibiotikaresistens måste breddas. Det räcker inte längre att bara fokusera på hur antibiotika används – även miljön måste bli en central del av strategin.
Läs mer på News55:
Glöm inte stortån – liten kroppsdel med stor betydelse
Ny studie: Du kan bli starkare och skarpare efter 65
Ny studie: Tandlossning påverkar hela kroppen

Ekberg
Har arbetat med News55 sedan 2018 och är idag ansvarig utgivare. Tycker att det är viktigt att lyfta fram äldrefrågor och bekämpa ålderismen som breder ut sig i samhället. Stolt över News55:s manifest: Vi står alltid på målgruppens sida.

Ekberg
Har arbetat med News55 sedan 2018 och är idag ansvarig utgivare. Tycker att det är viktigt att lyfta fram äldrefrågor och bekämpa ålderismen som breder ut sig i samhället. Stolt över News55:s manifest: Vi står alltid på målgruppens sida.




